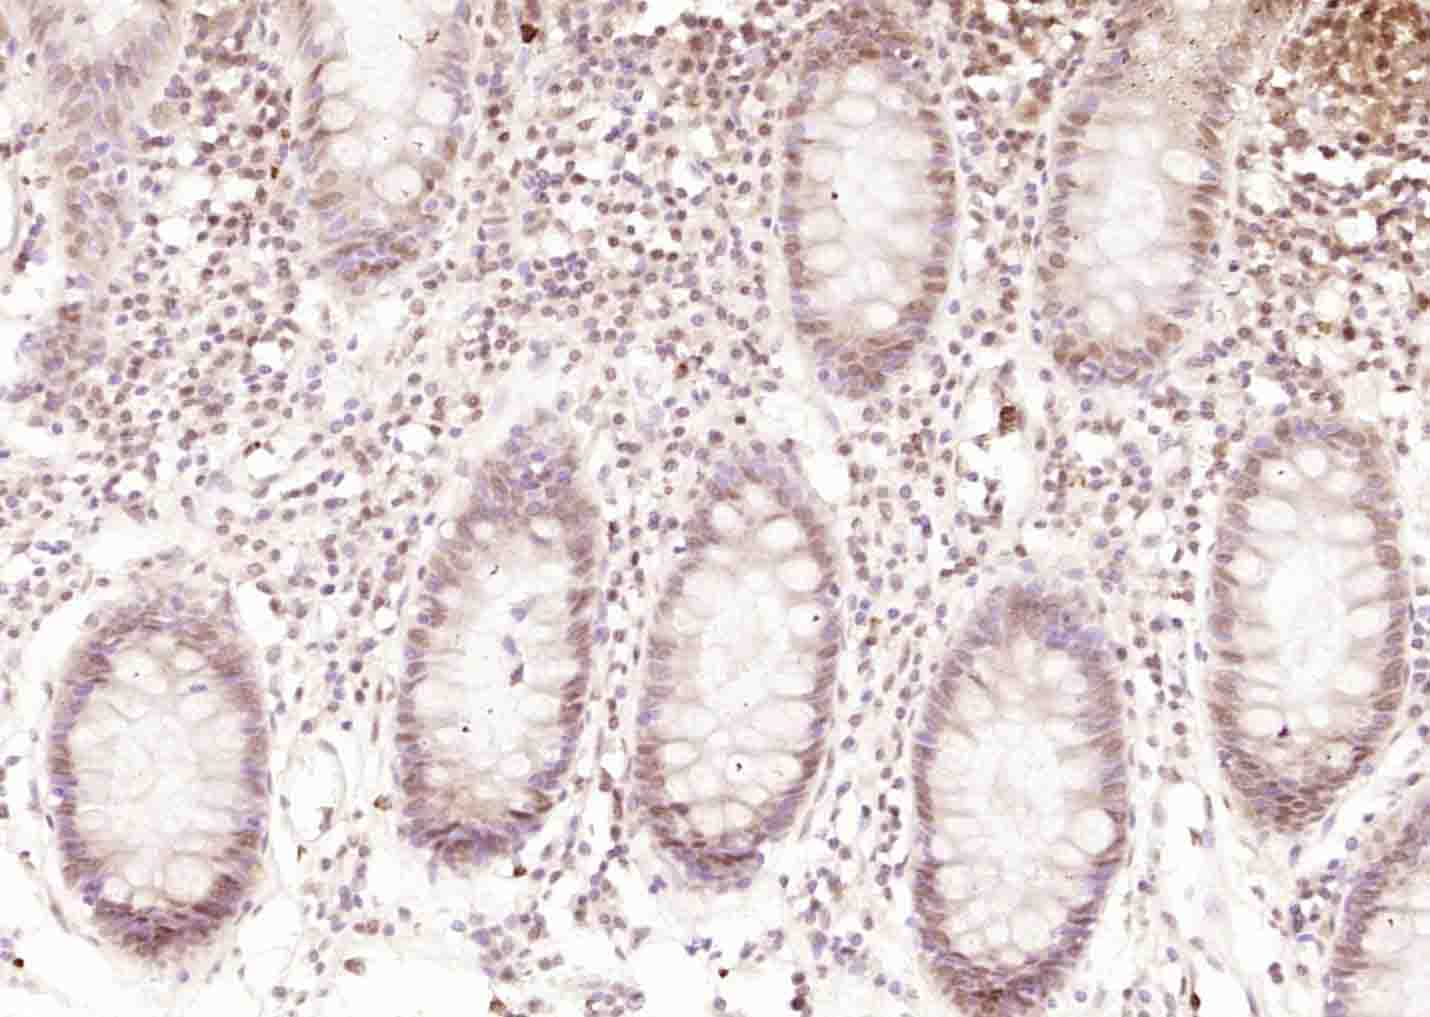
产品细节图片2

相关产品推荐更多 >
万千商家帮你免费找货
0 人在求购买到急需产品
- 详细信息
- 技术资料
- 应用范围:
产品信息以Bioss网站为准
- 规格:
50ul/100ul/200ul
| 规格: | 50ul | 产品价格: | ¥1180.0 |
|---|---|---|---|
| 规格: | 100ul | 产品价格: | ¥1980.0 |
| 规格: | 200ul | 产品价格: | ¥2800.0 |
| 产品编号 | bs-22050R |
| 英文名称 | ErbB 4 Rabbit pAb |
| 中文名称 | HER4抗体 |
| 英文别名 | Avian erythroblastic leukemia viral oncogene homolog 4; Avian erythroblastic leukemia viral v erb b2 oncogene homolog 4; ErbB4; HER 4; HER4; MGC138404; P180erbB4; Receptor protein tyrosine kinase erbB 4 precursor; Receptor tyrosine protein kinase erbB 4; Tyrosine kinase type cell surface receptor HER4; v erb a avian erythroblastic leukemia viral oncogene homolog like 4; v erb a erythroblastic leukemia viral oncogene homolog 4; C-erbB-4; Verba avian erythroblastic leukemia viral oncogene homolog like 4; Verba erythroblastic leukemia viral oncogene homolog 4; VERBB2; ERBB4_HUMAN. |
| 产品应用 | WB=1:500-2000, IHC-P=1:100-500, IHC-F=1:100-500, IF=1:100-500 Not yet tested in other applications. |
| 交叉反应 | Human, Rat (Mouse, Chicken, Horse, Rabbit, Sheep) |
| 抗体来源 | Rabbit |
| 免疫原 | KLH conjugated synthetic peptide derived from human ErbB 4 |
| 亚型 | IgG |
| 性状 | Liquid |
| 纯化方法 | affinity purified by Protein A |
| 克隆类型 | Polyclonal |
| 理论分子量 | 142 kDa |
| 浓度 | 1mg/ml |
| 储存液 | 0.01M TBS (pH7.4) with 1% BSA, 0.02% Proclin300 and 50% Glycerol. |
| 研究领域 | Cancer > Growth factors > EGF Cancer > Oncoproteins/suppressors > Oncoproteins > Growth factors Cancer > Tumor biomarkers > Oncoproteins Signal Transduction > Growth Factors/Hormones > EGF Signal Transduction > Protein Phosphorylation > Tyrosine Kinases > Receptor Tyrosine Kinases |
| 亚基 | Monomer in the absence of bound ligand. Homodimer or heterodimer with another ERBB family member upon ligand binding, thus forming heterotetramers. Interacts with EGFR and ERBB2. Interacts with CBFA2T3 (By similarity). Interacts with DLG2 (via its PDZ domain), DLG3 (via its PDZ domain), DLG4 (via its PDZ domain) and SNTB2 (via its PDZ domain). Interacts with MUC1. Interacts (via its PPxy motifs) with WWOX. Interacts (via the PPxY motif 3 of isoform JM-A CYT-2) with YAP1 (via the WW domain 1 of isoform 1). Interacts (isoform JM-A CYT-1 and isoform JM-B CYT-1) with WWP1. Interacts (via its intracellular domain) with TRIM28. Interacts (via the intracellular domains of both CYT-1 and CYT-2 isoforms) with KAP1; the interaction does not phosphorylate KAP1 but represses ERBB4-mediated transcriptional activity. Interacts with PRPU, DDX23, MATR3, RBM15, ILF3, KAP1, U5S1, U2SURP, ITCH, HNRPU, AP2A1, NULC, LEO1, WWP2, IGHG1, HXK1, GRB7 AND ARS2. Interacts (phosphorylated isoform JM-A CYT-1 and isoform JM-B CYT-1) with PIK3R1. Interacts with SHC1. Interacts with GRB2. Interacts (soluble intracellular domain) with STAT5A. Interacts (soluble intracellular domain) with BCL2. Interacts (phosphorylated) with STAT1. |
| 亚细胞定位 | Cell membrane; Single-pass type I membrane protein. Note=In response to NRG1 treatment, the activated receptor is internalized. ERBB4 intracellular domain: Nucleus. Mitochondrion. Note=Following proteolytical processing E4ICD (E4ICD1 or E4ICD2 generated from the respective isoforms) is translocated to the nucleus. Significantly more E4ICD2 than E4ICD1 is found in the nucleus. E4ICD2 colocalizes with YAP1 in the nucleus. |
| 组织特异性 | Expressed at highest levels in brain, heart, kidney, in addition to skeletal muscle, parathyroid, cerebellum, pituitary, spleen, testis and breast. Lower levels in thymus, lung, salivary gland, and pancreas. Isoform JM-A CYT-1 and isoform JM-B CYT-1 are expressed in cerebellum, but only the isoform JM-B is expressed in the heart. |
| 翻译后修饰 | Isoform JM-A CYT-1 and isoform JM-A CYT-2 are processed by ADAM17. Proteolytic processing in response to ligand or 12-O-tetradecanoylphorbol-13-acetate stimulation results in the production of 120 kDa soluble receptor forms and intermediate membrane-anchored 80 kDa fragments (m80HER4), which are further processed by a presenilin-dependent gamma-secretase to release a cytoplasmic intracellular domain (E4ICD; E4ICD1/s80Cyt1 or E4ICD2/s80Cyt2, depending on the isoform). Membrane-anchored 80 kDa fragments of the processed isoform JM-A CYT-1 are more readily degraded by the proteasome than fragments of isoform JM-A CYT-2, suggesting a prevalence of E4ICD2 over E4ICD1. Isoform JM-B CYT-1 and isoform JM-B CYT-2 lack the ADAM17 cleavage site and are not processed by ADAM17, precluding further processing by gamma-secretase.
Autophosphorylated on tyrosine residues in response to ligand binding. Autophosphorylation occurs in trans, i.e. one subunit of the dimeric receptor phosphorylates tyrosine residues on the other subunit. Ligands trigger phosphorylation at specific tyrosine residues, thereby creating binding sites for scaffold proteins and effectors. Constitutively phosphorylated at a basal level when overexpressed in heterologous systems; ligand binding leads to increased phosphorylation. Phosphorylation at Tyr-1035 is important for interaction with STAT1. Phosphorylation at Tyr-1056 is important for interaction with PIK3R1. Phosphorylation at Tyr-1242 is important for interaction with SHC1. Phosphorylation at Tyr-1188 may also contribute to the interaction with SHC1. Isoform JM-A CYT-2 is constitutively phosphorylated on tyrosine residues in a ligand-independent manner. E4ICD2 but not E4ICD1 is phosphorylated on tyrosine residues. Ubiquitinated. During mitosis, the ERBB4 intracellular domain is ubiquitinated by the APC/C complex and targeted to proteasomal degradation. Isoform JM-A CYT-1 and isoform JM-B CYT-1 are ubiquitinated by WWP1. The ERBB4 intracellular domain (E4ICD1) is ubiquitinated, and this involves NEDD4. |
| 相似性 | Belongs to the protein kinase superfamily. Tyr protein kinase family. EGF receptor subfamily. Contains 1 protein kinase domain. |
| 功能 | Tyrosine-protein kinase that plays an essential role as cell surface receptor for neuregulins and EGF family members and regulates development of the heart, the central nervous system and the mammary gland, gene transcription, cell proliferation, differentiation, migration and apoptosis. Required for normal cardiac muscle differentiation during embryonic development, and for postnatal cardiomyocyte proliferation. Required for normal development of the embryonic central nervous system, especially for normal neural crest cell migration and normal axon guidance. Required for mammary gland differentiation, induction of milk proteins and lactation. Acts as cell-surface receptor for the neuregulins NRG1, NRG2, NRG3 and NRG4 and the EGF family members BTC, EREG and HBEGF. Ligand binding triggers receptor dimerization and autophosphorylation at specific tyrosine residues that then serve as binding sites for scaffold proteins and effectors. Ligand specificity and signaling is modulated by alternative splicing, proteolytic processing, and by the formation of heterodimers with other ERBB family members, thereby creating multiple combinations of intracellular phosphotyrosines that trigger ligand- and context-specific cellular responses. Mediates phosphorylation of SHC1 and activation of the MAP kinases MAPK1/ERK2 and MAPK3/ERK1. Isoform JM-A CYT-1 and isoform JM-B CYT-1 phosphorylate PIK3R1, leading to the activation of phosphatidylinositol 3-kinase and AKT1 and protect cells against apoptosis. Isoform JM-A CYT-1 and isoform JM-B CYT-1 mediate reorganization of the actin cytoskeleton and promote cell migration in response to NRG1. Isoform JM-A CYT-2 and isoform JM-B CYT-2 lack the phosphotyrosine that mediates interaction with PIK3R1, and hence do not phosphorylate PIK3R1, do not protect cells against apoptosis, and do not promote reorganization of the actin cytoskeleton and cell migration. Proteolytic processing of isoform JM-A CYT-1 and isoform JM-A CYT-2 gives rise to the corresponding soluble intracellular domains (4ICD) that translocate to the nucleus, promote nuclear import of STAT5A, activation of STAT5A, mammary epithelium differentiation, cell proliferation and activation of gene expression. The ERBB4 soluble intracellular domains (4ICD) colocalize with STAT5A at the CSN2 promoter to regulate transcription of milk proteins during lactaction. The ERBB4 soluble intracellular domains can also translocate to mitochondria and promote apoptosis. |
| 保存条件 | Shipped at 4℃. Store at -20℃ for one year. Avoid repeated freeze/thaw cycles. |
| 注意事项 | This product as supplied is intended for research use only, not for use in human, therapeutic or diagnostic applications. |
| 背景资料 | This gene is a member of the Tyr protein kinase family and the epidermal growth factor receptor subfamily. It encodes a single-pass type I membrane protein with multiple cysteine rich domains, a transmembrane domain, a tyrosine kinase domain, a phosphotidylinositol-3 kinase binding site and a PDZ domain binding motif. The protein binds to and is activated by neuregulins and other factors and induces a variety of cellular responses including mitogenesis and differentiation. Multiple proteolytic events allow for the release of a cytoplasmic fragment and an extracellular fragment. Mutations in this gene have been associated with cancer. Alternatively spliced variants which encode different protein isoforms have been described; however, not all variants have been fully characterized. [provided by RefSeq, Jul 2008]. |
| 应用 | 推荐稀释比例 |
| {WB} | {1:500-2000} |
| {IHC-P} | {1:100-500} |
| {IHC-F} | {1:100-500} |
| {IF} | {1:100-500} |

Paraformaldehyde-fixed, paraffin embedded (rat brain); Antigen retrieval by boiling in sodium citrate buffer (pH6.0) for 15min; Block endogenous peroxidase by 3% hydrogen peroxide for 20 minutes; Blocking buffer (normal goat serum) at 37°C for 30min; Antibody incubation with (ErbB 4) Polyclonal Antibody, Unconjugated (bs-22050R) at 1:400 overnight at 4°C, followed by operating according to SP Kit(Rabbit) (sp-0023) instructionsand DAB staining.
Paraformaldehyde-fixed, paraffin embedded (human rectal carcinoma); Antigen retrieval by boiling in sodium citrate buffer (pH6.0) for 15min; Block endogenous peroxidase by 3% hydrogen peroxide for 20 minutes; Blocking buffer (normal goat serum) at 37°C for 30min; Antibody incubation with (ErbB 4) Polyclonal Antibody, Unconjugated (bs-22050R) at 1:400 overnight at 4°C, followed by operating according to SP Kit(Rabbit) (sp-0023) instructionsand DAB staining.

Sample:
Cerebrum (Rat) Lysate at 40 ug
Primary: Anti- ErbB 4 (bs-22050R) at 1/1000 dilution
Secondary: IRDye800CW Goat Anti-Rabbit IgG at 1/20000 dilution
Predicted band size: 142 kD
Observed band size: 142 kD
Cerebrum (Rat) Lysate at 40 ug
Primary: Anti- ErbB 4 (bs-22050R) at 1/1000 dilution
Secondary: IRDye800CW Goat Anti-Rabbit IgG at 1/20000 dilution
Predicted band size: 142 kD
Observed band size: 142 kD
风险提示:丁香通仅作为第三方平台,为商家信息发布提供平台空间。用户咨询产品时请注意保护个人信息及财产安全,合理判断,谨慎选购商品,商家和用户对交易行为负责。对于医疗器械类产品,请先查证核实企业经营资质和医疗器械产品注册证情况。
技术资料暂无技术资料 索取技术资料
ErbB 4 Rabbit pAb(bs-22050R)-50ul/100ul/200ul
¥1180 - 2800






